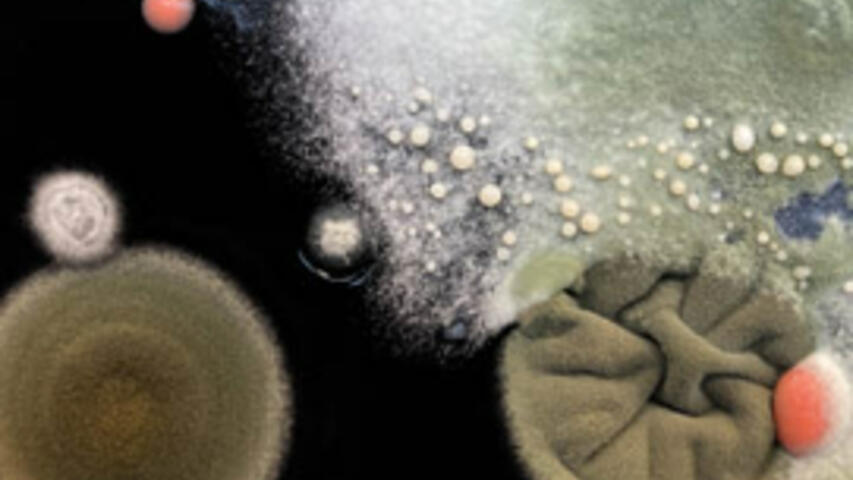
EL PENSAMENT SALVATGE

Espectáculo finalizado
Zip
Cinco días de nuevos formatos escénicos.
¿Cómo convivimos con el resto especies? ¿Qué relación tiene nuestro planeta con el universo? ¿Qué tiene que ver una colonia de hongos con un vertedero?
La ecología en todas sus acepciones es el hilo conductor de la primera edición del Festival ZIP. Desde el gesto más pequeño al más universal.
Del 15 al 19 de junio el TNC se convierte en un punto de encuentro de la escena híbrida con nombres como: Sociedad Doctor Alonso, Psirc, Elena Córdoba, Rosa Casado y Mike Brookes, Xesca Salvà y Marc Villanueva Mir, Laboratorio de Pensamiento Lúdico y Elisa Martínez & Co.
Instalaciones, encuentros y actividades
Del 15 al 19 de junio: Instalaciones en los diferentes espacios del TNC. Entrada gratuita.
Del 15 al 19 de junio: Encuentros internacionales de jóvenes (YPAL + ESCENA 25) en los diferentes espacios del TNC.
15, 17, 18 y 19 de junio: Xerrades a la fresca en el bar-peristilio del TNC. Entrada gratuita. Con la paticipación de ISEA2022 Barcelona (International Symposium on Electronic Art).
17 y 21 de junio: Seqüències fantasma d’una fi del món y Maddi Barber. Curtmetratges. Filmoteca de Catalunya.
Espectáculos
Sociedad Doctor Alonso
Sala Gran. Duración: 55 min
15 y 16/06/22 a las 20 h
Precio 8 €
Sociedad Doctor Alonso crea una propuesta interactiva, un recorrido para explorar nuestra relación con el espacio.
Centrada en el concepto de “Hammam” como contenedor de un ambiente y de una temperatura, Hammamturgia capta el flujo de los cuerpos y propone transformaciones para activar una obra coreográfica que dialoga con el espacio y tiempo.
Como la teoría de la endosimbiosis de Lynn Margulis, que entiende la relación bacteriana como un motor de vida y de adaptación crucial, Sociedad Doctor Alonso investiga una relación simbiótica entre creadores, espectadores, espacio y obra para investigar como las condiciones externas modifican las relaciones entre los cuerpos.
Transita la Sala Gran de una manera nueva. Sube al escenario, entra y atraviesa la obra, observa las condiciones ambientales y deja que pasen cosas. Transfórmate al mismo tiempo que transformas la pieza.
De quan Artemisa i el Leviatà del pantà
De quan Prometeu, els Bitcoins i el Martell de la Mort
Psirc
Sala Gran. Duración: 1 h
18/06/22 a las 17 h y 19/06/22 a las 20 h
Precio: 8 €
Es en los márgenes donde se nos permite existir y crear sin normas.
Psirc presenta dos de los cuatro capítulos de la saga Després de tot, que explora la marginalidad como un espacio de potencial i de posibilidades. Combinando música y circo, la compañía aborda el frágil equilibrio de la ecologia global y la crisis espiritual.
Personajes mitológicos clásicos y tecnología de última generación conviven en un lugar fronterizo, periferia de cualquier civilización; un paisaje en extinción que probablemente Google sitúe en el culo del mundo. Una epopeya sobre la cotidianeidad de existencias concebidas desde el margen.
Aquello desconocido genera miedo, pero también fascinación. Sumérgete en el pantano.
Rosa Casado y Mike Brookes
Sala Tallers. Duración: 1 h
Del 15 al 19/06/22 a las 18.30h
Espectáculo en castellano
Precio: 8 €
Una acción poética delicada y minuciosa que nos conecta con otros lugares y otros tiempos.
Durante cinco días Rosa, Mike y un grupo de colaboradoras desmontarán un coche de segunda mano en todas y cada una de sus partes, una acción minuciosa de separación y clasificación de los materiales que constituyen el vehículo para pensar en lo residual y en la conectividad material de lugares distantes. A lo largo de estos cinco días habrá cinco perfomances distintas, cinco episodios en los que se propondrán diferentes perspectivas y escalas de relación con el mundo a través de este objeto.
El episodio 1 [15/06/22] comienza con el viaje final de uno de los mil millones de coches que actualmente se estima circulan por las calles del mundo.
En el episodio 2 [16/06/22] miramos hacia arriba para observar la fina capa atmosférica que rodea el planeta y como las cosas que quedan suspendidas y circulan en ella afectan lo que vemos.
En el episodio 3 [17/06/22] imaginamos la humanidad como una fuerza de la naturaleza y pensamos en la escala de los procesos y eventos geológicos comparables a esta fuerza.
En el episodio 4 [18/06/22] rastreamos el polvo que se levanta y se asienta con todo lo que hacemos, residuos que se desplazan de un lugar a otro y que no podemos evitar.
En el episodio 5 [19/06/22] amontonamos todo aquello para lo que podríamos encontrar un nuevo uso o propósito, intentamos deshacernos de ello y después miramos lo que queda.
Elena Córdoba
Sala Petita. Duración: 1 h 10 min
17 y 18/06/22 a las 20 h
Espectáculo en castellano
Precio: 8 €
Somos un jardín y Elena Córdoba y su compañía imaginan un futuro en el cual sus cuerpos de bailarines se vuelven verdes y se convierten en árboles.
Elena Córdoba pasó la pandemia observando mundos microscópicos. Texturas vegetales aumentadas bajo las lentes hasta el punto de perder la referencia de origen. Flores, musgos, hojas, líquenes…
Y pareceremos árboles combina la danza, el estudio de la anatomía y la proyección de estas realidades vegetales aumentadas con el microscopio para crear uniones ficticias entre el cuerpo y las formas de organización de las plantas.
El cuerpo humano está lleno de formas vegetales: neuronas arboriformes que se unen formando bosques, pequeños árboles eléctricos donde nacen nuestros pensamientos, ramificaciones del sistema nervioso que son como raíces intrincadas…
Xesca Salvà y Marc Villanueva Mir
1. Ritual de inoculación. 15/06/22 a las 17 h. Jardines Sala Tallers. Duración: 1 h 30 min
2. Periodo de crecimiento. ENTRADA GRATUITA.16, 17 y 18/06/22. Taller de pintura. Duración: 45 min
3. Exploració planetària. 19/06/22 a les 12.30 h Magatzems. Durada: 45 min
Precio: 8 € (Ritual d’inoculació y Exploració planetària)
Una placa de laboratorio de dimensiones gigantes. Manos llenas de microbios. Y tiempo. Estos son los tres elementos necesarios para crear una colonia de hongos que veremos crecer en directo en esta pieza de los creadores Xesca Salvà y Marc Villanueva.
1. Ritual de inoculación
Un encuentro colectivo y festivo donde compañía y espectadores se reunirán alrededor de una placa de Petri de dos metros de diámetro para realizar un ritual de inoculación. Una charla sobre las singularidades digestivas de los hongos, su habilidad como descomponedores y transformadores de la materia y el significado ecológico de los desechos.
2. Periodo de crecimiento
Durante cinco días la placa se conservará en el Taller de pintura (acceso por la calle técnica), en un ambiente semioscuro y silencioso, mientras los hongos y las bacterias inoculados crecen en su interior. En este periodo la placa se podrá visitar libremente y de manera gratuita. ¡Acércate a verlo!
3. Exploración planetaria
Es hora de ver el resultado. Mientras descubrimos qué ha crecido dentro de la placa de Petri, una intervención sonora con percusión y música electrónica en directo nos propone un dialogo entre los sonidos generados por los hongos y el paralelismo con la colonización y la urbanización humana.
Laboratorio de pensamiento lúdico
Vestíbulo superior. Duración: 3 h
18/06/22 a las 11 h
Precio: 8 €
Un juego que activa (con)fabulaciones y donde los jugadores tienen que aparentarse con especies no humanas (animales, plantas, bacterias, hongos...) para sobrevivir.
Game of Kin invita a pensar juntos sobre las opciones de vida y muerte de una serie de seres híbridos, surgidos de parentescos imaginados en un contexto de condiciones ambientales extremas. Mutaciones, hibridaciones, extinciones… Las soluciones no tienen por qué ser amistosas y seguramente implicarán siempre graves consecuencias.
Game of Kin es un juego en constante transformación que genera múltiples narrativas dependiendo de las discusiones, negociaciones y acuerdos a los que llegan los jugadores en cada partida.
Una propuesta que pretende cambiar nuestra manera de pensar y sembrar la semilla de un futuro donde realmente se pueda sobrevivir. Porque la regeneración todavía es posible pero solo si somos capaces de imaginarla.
Elisa Martínez & Co.
Vídeo instalación
Vestíbulo principal
De 16 h a 20 h
ENTRADA GRATUITA
Todavía hoy en día el vehículo se entiende como un símbolo de masculinidad y estatus.
En esta vídeo instalación, Elisa Martínez se apropia de la fórmula ‘anuncio de un coche de lujo’ y del eslogan “The Best or Nothing” de Mercedes Benz para enfrentar la publicidad y la subida de la venta de coches de lujo con los carros de chatarra, un nuevo elemento del paisaje urbano de Barcelona.
Esta pieza es incómoda porque evidencia nuestra propia deshumanización. Al mirar un coche de lujo o un carro de chatarra la persona desaparece y solo somos capaces de ver el material que le envuelve y le representa.
Precios
5 entradas para canjear entre 5 espectáculos o funciones. Ahorra un 37%.Información general
¡Compra ahora!Puedes canjear tus entradas por internet, por teléfono 933 065 720 y en las Taquillas del TNC. Y si cambias de opinión, no te preocupes, puedes cambiarlas hasta 24 h antes del inicio de la función.
Promoción limitada. Date prisa y no te quedes sin tu Pack ZIP.
Espectáculos incluidos: Hammamturgia, Després de tot, En un día claro puedes ver para siempre,Y pareceremos árboles. Ficciones Botánicas y El pensament salvatge.